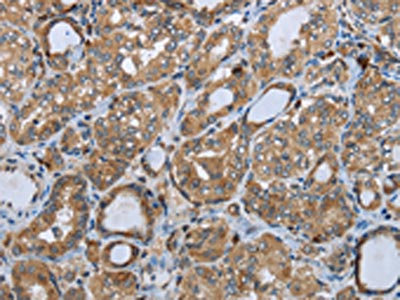

PPP1R13L Antibody
-
中文名稱:PPP1R13L兔多克隆抗體
-
貨號:CSB-PA290837
-
規格:¥1100
-
圖片:
-
The image on the left is immunohistochemistry of paraffin-embedded Human brain tissue using CSB-PA290837(PPP1R13L Antibody) at dilution 1/30, on the right is treated with synthetic peptide. (Original magnification: ×200)
-
The image on the left is immunohistochemistry of paraffin-embedded Human thyroid cancer tissue using CSB-PA290837(PPP1R13L Antibody) at dilution 1/30, on the right is treated with synthetic peptide. (Original magnification: ×200)
-
Gel: 6%SDS-PAGE, Lysate: 40 μg, Lane 1-2: Lncap cells, hela cells, Primary antibody: CSB-PA290837(PPP1R13L Antibody) at dilution 1/350, Secondary antibody: Goat anti rabbit IgG at 1/8000 dilution, Exposure time: 5 minutes
-
-
其他:
產品詳情
-
Uniprot No.:
-
基因名:PPP1R13L
-
別名:PPP1R13L antibody; IASPP antibody; NKIP1 antibody; PPP1R13BL antibody; RAI antibody; RelA-associated inhibitor antibody; Inhibitor of ASPP protein antibody; Protein iASPP antibody; NFkB-interacting protein 1 antibody; PPP1R13B-like protein antibody
-
宿主:Rabbit
-
反應種屬:Human,Mouse
-
免疫原:Synthetic peptide of Human PPP1R13L
-
免疫原種屬:Homo sapiens (Human)
-
標記方式:Non-conjugated
-
抗體亞型:IgG
-
純化方式:Antigen affinity purification
-
濃度:It differs from different batches. Please contact us to confirm it.
-
保存緩沖液:-20°C, pH7.4 PBS, 0.05% NaN3, 40% Glycerol
-
產品提供形式:Liquid
-
應用范圍:ELISA,WB,IHC
-
推薦稀釋比:
Application Recommended Dilution ELISA 1:1000-1:2000 WB 1:200-1:1000 IHC 1:25-1:100 -
Protocols:
-
儲存條件:Upon receipt, store at -20°C or -80°C. Avoid repeated freeze.
-
貨期:Basically, we can dispatch the products out in 1-3 working days after receiving your orders. Delivery time maybe differs from different purchasing way or location, please kindly consult your local distributors for specific delivery time.
-
用途:For Research Use Only. Not for use in diagnostic or therapeutic procedures.
相關產品
靶點詳情
-
功能:Regulator that plays a central role in regulation of apoptosis and transcription via its interaction with NF-kappa-B and p53/TP53 proteins. Blocks transcription of HIV-1 virus by inhibiting the action of both NF-kappa-B and SP1. Also inhibits p53/TP53 function, possibly by preventing the association between p53/TP53 and ASPP1 or ASPP2, and therefore suppressing the subsequent activation of apoptosis.
-
基因功能參考文獻:
- Haplotypes consisting of PPP1R13L rs1970764 and ATM rs11212592 may be associated with lung cancer. Haplotypes consisting of PPP1R13L, CD3EAP and GLTSCR1 SNPs on Chr19q13.3 may associate with lung cancer risk in the Chinese population. PMID: 30128886
- The expression of CD3EAP exon 1 was demonstrated to be significantly associated with PPP1R13L exon 1, while CD3EAP exon 3 was significantly associated with ERCC1 exon 11 in normal and non-small cell lung cancer (NSCLC) tissues. It was observed that short transcripts of ERCC1, CD3EAP and PPP1R13L are co-expressed in A549 NSCLC cell line. PMID: 29620255
- Increased expression of miR-150 suppressed viability, proliferation, migration and invasion of SW480 cells. Furthermore, iASPP was a direct target of miR-150 and played a key role in its anti-colorectal cancer (CRC)function. miR-150 may be a promising predictor of prognosis in CRC patients. PMID: 29750311
- IASPP knockdown suppressed cell viability and DNA synthesis capacity; the effect of miR-340 inhibition was partially attenuated by iASPP inhibition. PMID: 29982095
- The expression of iASPP was higher in highgrade astrocytic gliomas compared with lowgrade astrocytic gliomas. PMID: 29257240
- Data showed that iASPP could promote tumor growth by increasing autophagic flux, and iASPP could serve as a poor prognostic factor and a potential therapeutic target in lung cancer. PMID: 29072696
- Sertad1 could antagonize iASPP function by hindering its entrance into nuclei to interact with P53 in leukemic cells when iASPP was in the stage of overproduction. PMID: 29179704
- The interactive modulation among miR-124 and iASPP in p53-mutant or -deleted cells may serve as a crucial pathway, which mediates therapy resistance when p53 is mutated or deleted, in the process of photodynamic therapy treatment of Colorectal cancer. PMID: 29022915
- These findings indicated that XIST may regulate the tumor growth and metastasis via miR-140-dependent iASPP regulation. Taken together, our data indicated that XIST may be an oncogenic lncRNA that promotes the proliferation and metastasis of lung cancer through the regulation of miR-140 and could be regarded as a therapeutic target in human lung cancer. PMID: 28656261
- FHL2 and iASPP interacted with each other and co-localized in both nucleus and cytoplasm. Either FHL2 or iASPP silenced could reduce cell proliferation, induce cell cycle arrest at G0/G1 phase, and increase cell apoptosis. PMID: 28402264
- the restoration of miR-124 reduces iASPP expression and leads to p53-dependent tumor suppression, suggesting a therapeutic strategy to treat iASPP-associated cervical cancer. PMID: 27765948
- miR-124 regulates p63 via iASPP, while p63 targets miR-155 via the modulation of STAT1 expression in colorectal cancer. PMID: 28418858
- TP73-AS1 inhibited the brain glioma growth and metastasis as a competing endogenous RNA (ceRNA) through miR-124-dependent iASPP regulation. PMID: 29412778
- findings revealed the detailed role of the miR-184/iASPP axis in Central nervous system lymphoma (CNSL) and this axis might modulate the proliferation and invasion of CNSL via regulating the PI3K/Akt signaling pathway. PMID: 28012196
- Data suggest that Keap1, rather than Nrf2, is critical for the recruitment of iASPP into the Keap1-Nrf2 complex PMID: 29033244
- Three htSNPs (haplotype-tagging single nucleotide polymorphism) (rs7354, rs14384, and rs3783501) covering 95% of the common haplotype diversity in 19p13.3-GADD45B and interaction of 19p13.3-GADD45B and 19q13.3-PPP1R13L and 19q13.3-CD3EAP variants and smoking-duration were explored in lung cancer risk Chinese. PMID: 28870783
- We describe the identification of a maternally inherited frameshift mutation in RAI1, causative for SMS. This is the first report about transmission of SMS from an affected parent to an offspring. PMID: 27683195
- These results determined PPP1R13L as the gene underlying a novel autosomal-recessive cardio-cutaneous syndrome in humans and strongly suggest that the fatal dilated cardiomyopathy during infancy is a consequence of failure to regulate transcriptional pathways necessary for tuning cardiac threshold response to common inflammatory stressors. PMID: 28069640
- UCA1 might promote proliferation and migration of glioma, to regulate the tumor growth and metastasis via miR-182 dependent iASPP regulation. PMID: 28137422
- Results demonstrate that iASPP is overexpressed in bladder cancer and promotes the malignancy of bladder cancer PMID: 28489738
- lncRNA H19 interacts with miR-140 to modulate glioma growth by targeting iASPP PMID: 27693036
- Increased expression of p53 and ASPP1 and downregulation of iASPP. PMID: 27177208
- Our study provides the first evidence that high iASPP-SV expression may be a novel prognostic factor and therapeutic target for glioma PMID: 26628298
- we were able to reproduce previously found associations between PPP1R13L and CD3EAP polymorphisms and lung cancer risk in an increased study group, and we found interactions between NFKB1 rs28362491-PPP1R13L rs1970764 and smoking duration and between CD3EAP rs735482 and smoking duration PMID: 26563375
- inhibitor of apoptosis-stimulating protein of p53 (iASPP) was identified to be a direct target of miR-140 in pancreatic duct adenocarcinoma specimens and cell lines PMID: 26787707
- we show that iASPP is a novel substrate of caspases in response to apoptotic stimuli PMID: 26646590
- one novel region within PPP1R13L is hypomethylated in all transient neonatal diabetes type 1 patients included in this study PMID: 27075368
- destabilization of p300/CBP by downregulation of iASPP expression levels appears to represent a molecular mechanism that contributes to chemoresistance in melanoma cells. PMID: 25675294
- One of the proteins identified, iASPP, showed reduced levels in the presence of GSK-3. Further, blocking iASPP activity increased cell death, particularly in p53 wild-type BC3 PEL cells. PMID: 26109723
- The present study showed that iASPP is overexpressed in oral cavity squamous cell carcinomas (OSCC)tissues and increased cytoplasmic iASPP is correlated with recurrence and poor survival outcomes in OSCC patients PMID: 25149434
- results suggest that NFKB1 common variants and smoking duration and smoking duration-PPP1R13L rs1970764 interaction could be concerned with the lung cancer development in a Chinese population PMID: 25917613
- iASPP expression may act as a predictive marker of prostate cancer progression. PMID: 25341046
- data highlight the importance of 14-3-3 proteins in antiviral responses and identify RelA-associated inhibitor and sirtuin 1 as novel regulators of antiviral innate immune responses. PMID: 24997996
- These data demonstrate that by interacting with desmoplakin and desmin, iASPP is an important regulator of desmosomal function both in vitro and in vivo. PMID: 25691752
- Authors have identified a novel mechanism modulating autophagy in keratinocytes that relies upon iASPP expression specifically reducing the interaction of Atg5-Atg12 with Atg16L1. PMID: 24777476
- MIRN124 binds to the 3'UTR of iASPP and suppressing mRNA expression and the proliferation of prostate tumor cells. PMID: 24966937
- Hematopoietic cells can be protected against apoptosis by iASPP. PMID: 24668753
- rs6966 (3' UTR of PPP1R13L, chr 19q13.32, P = 4.55 x 10(-9)) and rs414580 (intron 2 of MSR1, chr 8p22, P = 6.09 x 10(-8)) were significantly associated with ALL. PMID: 24604828
- Haplotype PPP1R13L rs4803817 polymorphism is associated with lung cancer risk. PMID: 24140460
- overexpression of iASPP and the low expression of caspase-9 in esophageal cancer are closely correlated with tumor invasion and metastasis PMID: 24405603
- higher rate Helicobacter pylori infection, an increased expression of inhibitor of apoptosis stimulating protein of p53 (iASPP), and decreased expression of apoptosis-stimulating of p53 protein 2(ASPP2) was present in gastric cancer PMID: 23528480
- This study thus demonstrates that iASPP is highly elevated in human cervical cancer, and that overexpression of nuclear iASPP is correlated with poor prognosis and chemoresistance/radioresistance PMID: 23420450
- Downregulation of miR-124 promotes the growth and invasiveness of glioblastoma cells involving upregulation of PPP1R13L. PMID: 23624869
- the miR-124/iASPP axis can regulate the proliferation of colorectal cancer cells. PMID: 23691514
- PPP1R13L and CD3EAP variants may be associated with lung cancer risk in nonsmoking Chinese women. PMID: 23624123
- results suggest iASPP may contribute to the malignant progression of head and neck squamous cell carcinoma PMID: 22815155
- The PPP1R13L rs1970764 variant is a possible prognostic marker for patients with rectal cancer. PMID: 23180017
- When the Px(T)PxR motif is deleted or mutated via insertion of a phosphorylation site mimic (T311D), PP-1c fails to bind to all three ASPP proteins, ASPP1, ASPP2 and iASPP. PMID: 23088536
- These findings showed that iAPSS/iASPPsv reduced the growth inhibition and apoptosis induced by Dex or VP-16, with DNA damage accumulating which might promote the pathogenesis and/or progression of cancer. PMID: 22766503
- iASPP inhibited apoptosis independently of p53 in tumor cells, mainly by inhibiting the transcriptional activity of p63/p73 on the promoters of proapoptotic genes PMID: 22538442
顯示更多
收起更多
-
亞細胞定位:Cytoplasm. Nucleus.
-
蛋白家族:ASPP family
-
組織特異性:Highly expressed in heart, placenta and prostate. Weakly expressed in brain, liver, skeletal muscle, testis and peripheral blood leukocyte.
-
數據庫鏈接:
Most popular with customers
-
-
Phospho-YAP1 (S127) Recombinant Monoclonal Antibody
Applications: ELISA, WB, IHC
Species Reactivity: Human
-
-
-
-
-
-